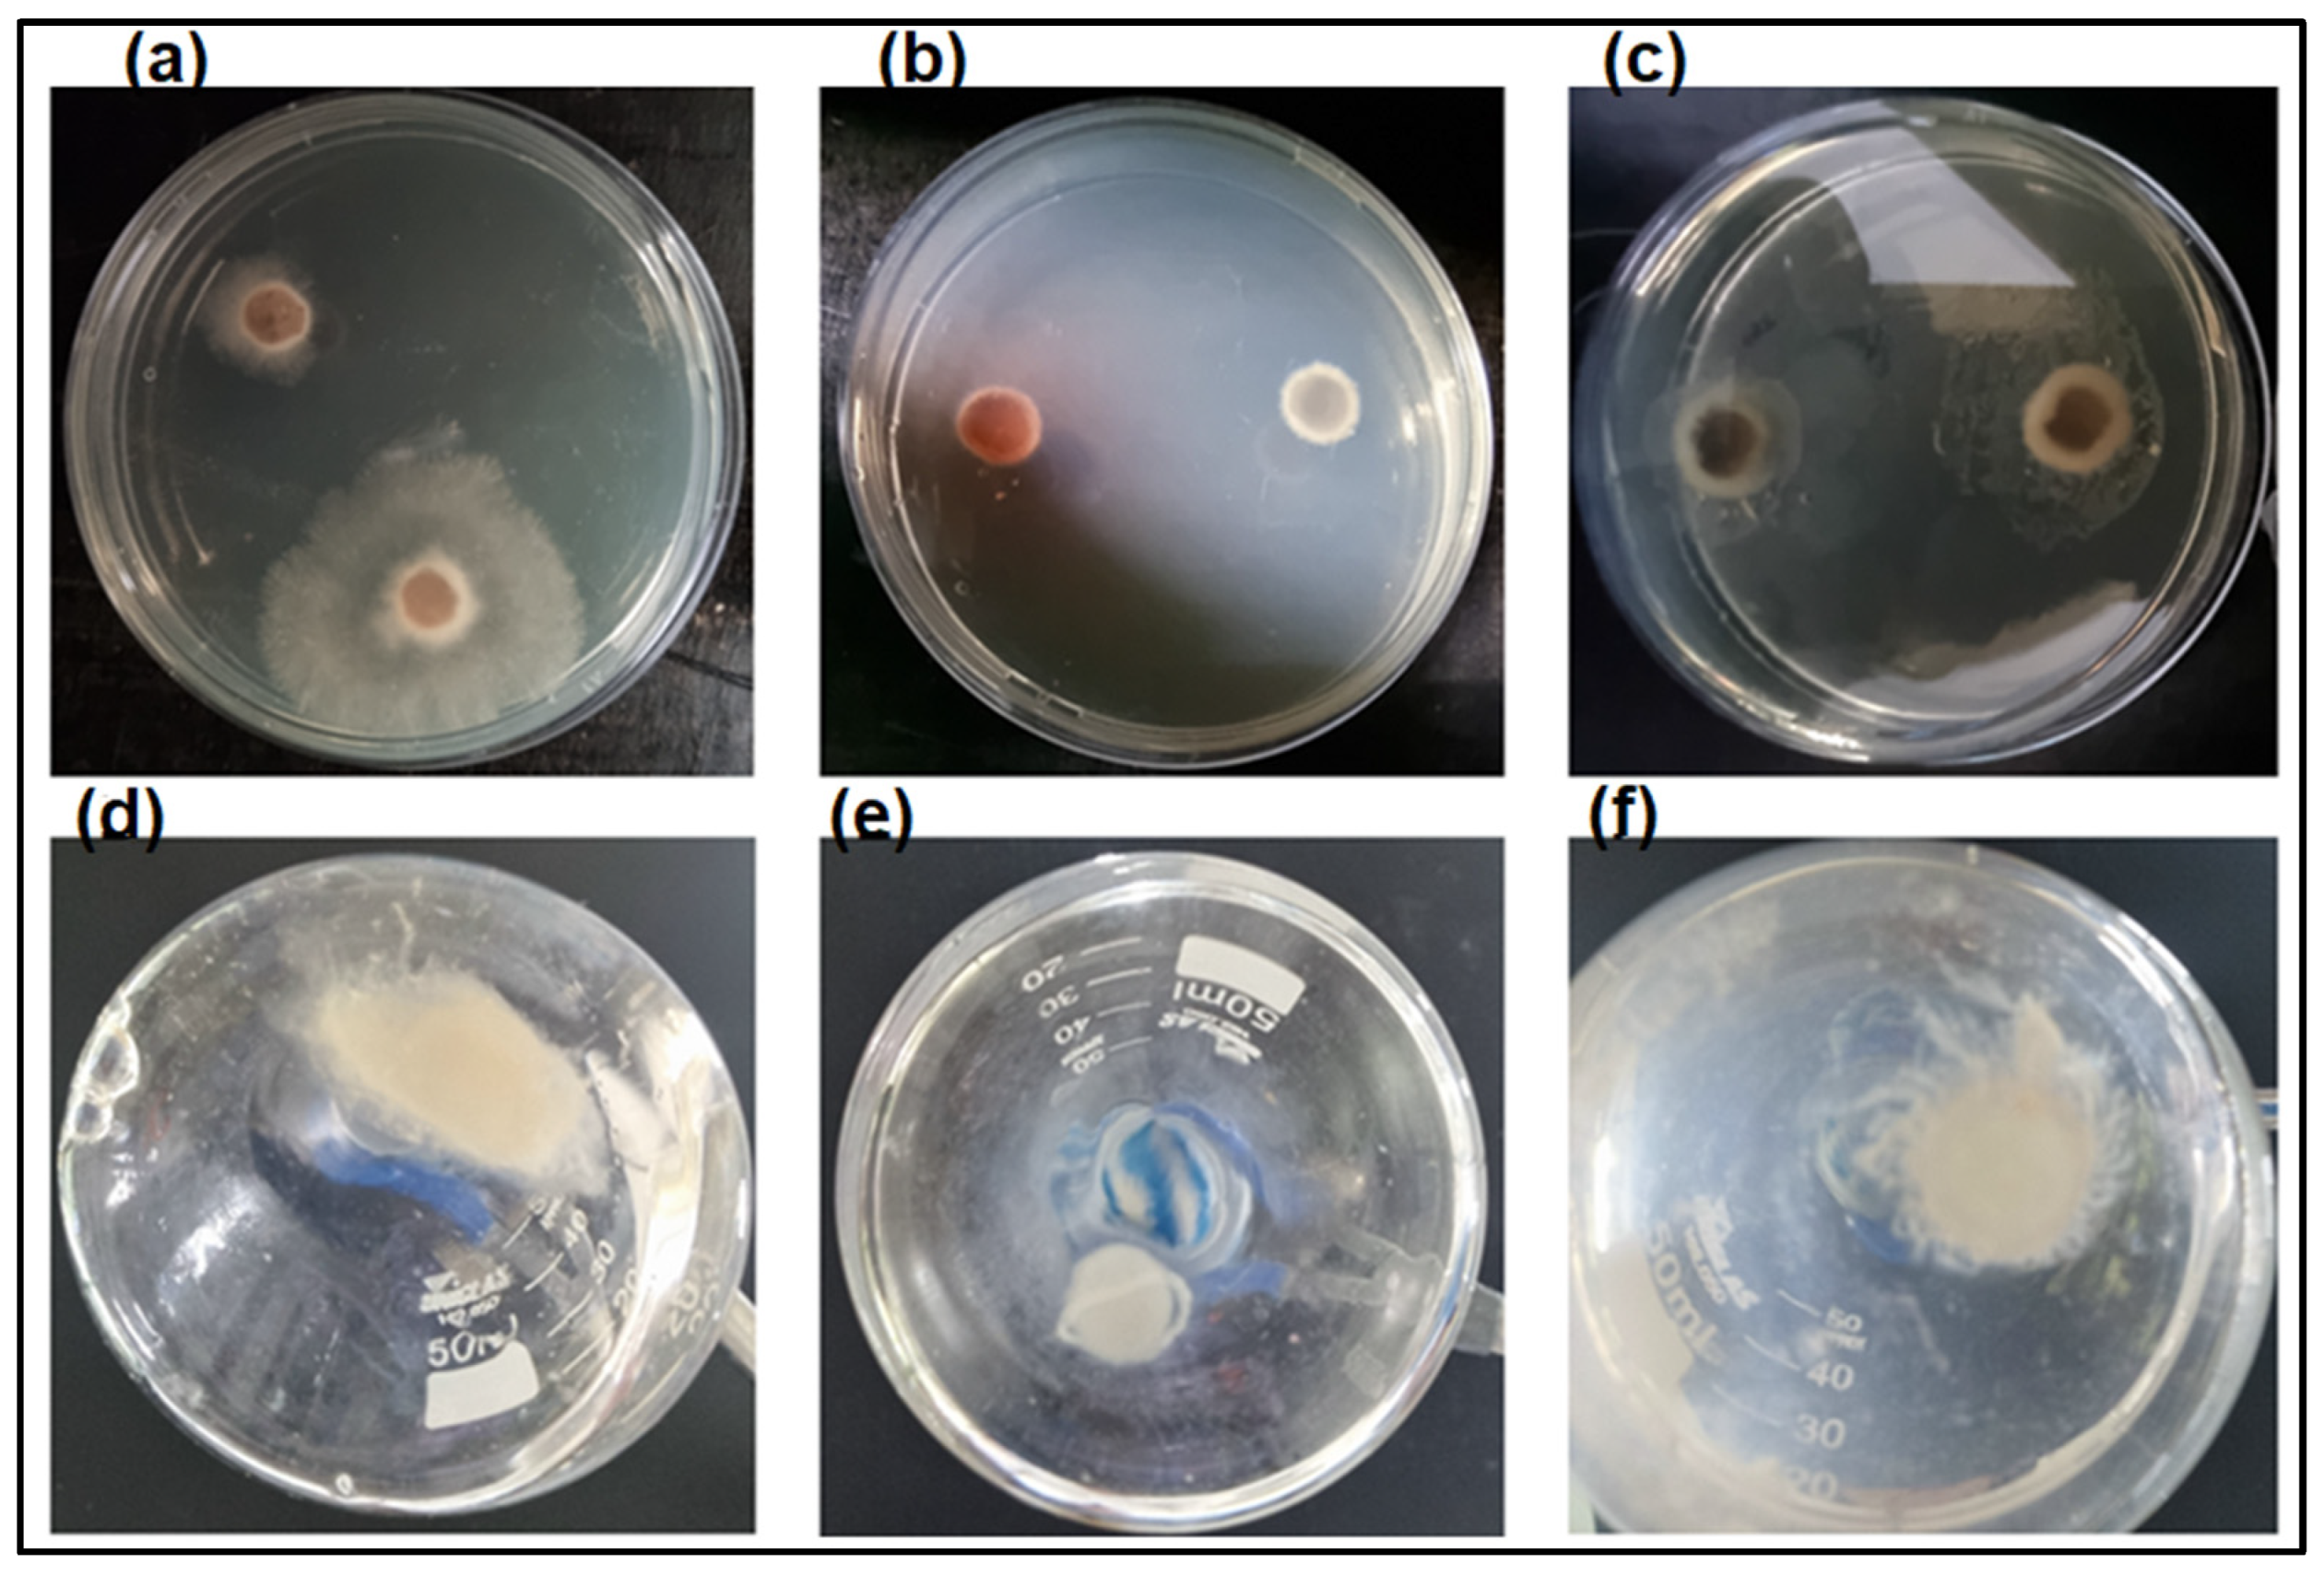
Polymers 16 00529 g005

Activity of a Recombinant Chitinase of the Atta sexdens Ant on Different Forms of Chitin and Its Fungicidal Effect against Lasiodiplodia theobromae
Abstract
1. Introduction
2. Materials and Methods
2.1. Materials
2.2. Methods
2.2.1. Evaluation of Enzyme Activity against Various Forms of Chitin
α- and β-Chitin Substrates
Enzymatic Activity against Various TYPES of Chitin
2.2.2. Evaluation of GlcNAc Production via 1H Nuclear Magnetic Resonance (NMR) Spectroscopy Post Enzymatic Reaction
2.2.3. Analysis of the Morphology of Various Types of Chitin
Solid-State 13C Nuclear Magnetic Resonance (NMR) Spectroscopy
X-ray Diffraction (XRD)
Capillary Viscometry in Dilute Regime
2.3. Evaluation of the AsChtII-C4B1 Enzyme Activity on the Growth of the Fungus L. theobromae
2.3.1. Assays of Activity and Thermostability of AsChtII-C4B1
2.3.2. Antifungal Assays
2.3.3. Analysis of Biological Samples via Scanning Electron Microscopy (SEM)
3. Results and Discussion
3.1. Activity of Recombinant Chitinase on Various Substrates
3.2. H NMR Spectroscopy of Enzymatic Hydrolysis on α- and β-Chitin Colloidal Substrates
3.3. Activity of AsChtII-C4B1 on Different Types of Chitin
3.4. Capillary Viscometry in Dilute Regime
3.5. Analysis of Enzyme Activity on the Growth of Fungus L. theobromae
4. Conclusions
Supplementary Materials
Author Contributions
Funding
Data Availability Statement
Conflicts of Interest
References
- Patel, S.; Goyal, A. Chitin and chitinase: Role in pathogenicity, allergenicity and health. Int. J. Biol. Macromol. 2017, 97, 331–338. [Google Scholar] [CrossRef]
- Zuhairah Zainuddin, S.; Abdul Hamid, K. Chitosan-Based Oral Drug Delivery System for Peptide, Protein and Vaccine Delivery. Chitin and Chitosan-Physicochemical Properties and Industrial Applications; BoD–Books on Demand: Norderstedt, Germany, 2021. [Google Scholar] [CrossRef]
- Kaya, M.; Mujtaba, M.; Ehrlich, H.; Salaberria, A.M.; Baran, T.; Amemiya, C.T.; Galli, R.; Akyuz, L.; Sargin, I.; Labidi, J. On chemistry of γ-chitin. Carbohydr. Polym. 2017, 176, 177–186. [Google Scholar] [CrossRef] [PubMed]
- Merzendorfer, H. Insect chitin synthases: A review. J. Comp. Physiol. B 2006, 176, 1–15. [Google Scholar] [CrossRef] [PubMed]
- Bai, L.; Liu, L.; Esquivel, M.; Tardy, B.L.; Huan, S.; Niu, X.; Liu, S.; Yang, G.; Fan, Y.; Rojas, O.J. Nanochitin: Chemistry, Structure, Assembly, and Applications. Chem. Rev. 2022, 122, 11604–11674. [Google Scholar] [CrossRef] [PubMed]
- Zhang, X.; Yuan, J.; Li, F.; Xiang, J. Chitin Synthesis and Degradation in Crustaceans: A Genomic View and Application. Mar. Drugs 2021, 19, 153. [Google Scholar] [CrossRef] [PubMed]
- Chen, J.K.; Shen, C.R.; Liu, C.L. N-acetylglucosamine: Production and applications. Mar. Drugs 2010, 8, 2493–2516. [Google Scholar] [CrossRef] [PubMed]
- Liu, L.; Liu, Y.; Shin, H.D.; Chen, R.; Li, J.; Du, G.; Chen, J. Microbial production of glucosamine and N-acetylglucosamine: Advances and perspectives. Appl. Microbiol. Biotechnol. 2013, 97, 6149–6158. [Google Scholar] [CrossRef] [PubMed]
- Ahmad, S.I.; Ahmad, R.; Khan, M.S.; Kant, R.; Shahid, S.; Gautam, L.; Hasan, G.M.; Hassan, M.I. Chitin and its derivatives: Structural properties and biomedical applications. Int. J. Biol. Macromol. 2020, 164, 526–539. [Google Scholar] [CrossRef]
- Kidibule, P.E.; Santos-Moriano, P.; Plou, F.J.; Fernández-Lobato, M. Endo-chitinase Chit33 specificity on different chitinolytic materials allows the production of unexplored chitooligosaccharides with antioxidant activity. Biotechnol. Rep. 2020, 27, e00500. [Google Scholar] [CrossRef]
- Sánchez, Á.; Mengíbar, M.; Rivera-Rodríguez, G.; Moerchbacher, B.; Acosta, N.; Heras, A. The effect of preparation processes on the physicochemical characteristics and antibacterial activity of chitooligosaccharides. Carbohydr. Polym. 2017, 157, 251–257. [Google Scholar] [CrossRef]
- Wang, Y.-T.; Wu, P.-L. Gene Cloning, Characterization, and Molecular Simulations of a Novel Recombinant Chitinase from Chitinibacter Tainanensis CT01 Appropriate for Chitin Enzymatic Hydrolysis. Polymers 2020, 12, 1648. [Google Scholar] [CrossRef]
- Chen, W.; Jiang, X.; Yang, Q. Glycoside hydrolase family 18 chitinases: The known and the unknown. Biotechnol. Adv. 2020, 43, 107553. [Google Scholar] [CrossRef]
- Li, F.; You, X.; Li, Q.; Qin, D.; Wang, M.; Yuan, S.; Chen, X.; Bi, S. Homogeneous deacetylation and degradation of chitin in NaOH/urea dissolution system. Int. J. Biol. Macromol. 2021, 189, 391–397. [Google Scholar] [CrossRef]
- Allison, C.L.; Lutzke, A.; Reynolds, M.M. Identification of low molecular weight degradation products from chitin and chitosan by electrospray ionization time-of-flight mass spectrometry. Carbohydr. Res. 2020, 493, 108046. [Google Scholar] [CrossRef] [PubMed]
- Yu, X.; Jiang, Z.; Xu, X.; Huang, C.; Yao, Z.; Yang, X.; Zhang, Y.; Wang, D.; Wei, C.; Zhuang, X. Mechano-Enzymatic Degradation of the Chitin from Crustacea Shells for Efficient Production of N-acetylglucosamine (GlcNAc). Molecules 2022, 27, 4720. [Google Scholar] [CrossRef] [PubMed]
- Hou, F.; Gong, Z.; Jia, F.; Cui, W.; Song, S.; Zhang, J.; Wang, Y.; Wang, W. Insights into the relationships of modifying methods, structure, functional properties and applications of chitin: A review. Food Chem. 2023, 409, 135336. [Google Scholar] [CrossRef] [PubMed]
- Kaczmarek, M.B.; Struszczyk-Swita, K.; Li, X.; Szczęsna-Antczak, M.; Daroch, M. Enzymatic Modifications of Chitin, Chitosan, and Chitooligosaccharides. Front. Bioeng. Biotechnol. 2019, 7, 243. [Google Scholar] [CrossRef] [PubMed]
- Arnold, N.D.; Brück, W.M.; Garbe, D.; Brück, T.B. Enzymatic Modification of Native Chitin and Conversion to Specialty Chemical Products. Mar. Drugs 2020, 18, 93. [Google Scholar] [CrossRef] [PubMed]
- Krolicka, M.; Hinz, S.W.A.; Koetsier, M.J.; Joosten, R.; Eggink, G.; Van Den Broek, L.A.M.; Boeriu, C.G. Chitinase Chi1 from Myceliophthora thermophila C1, a Thermostable Enzyme for Chitin and Chitosan Depolymerization. J. Agric. Food Chem. 2018, 66, 1658–1669. [Google Scholar] [CrossRef]
- Poria, V.; Rana, A.; Kumari, A.; Grewal, J.; Pranaw, K.; Singh, S. Current perspectives on chitinolytic enzymes and their agro-industrial applications. Biology 2021, 10, 1319. [Google Scholar] [CrossRef]
- Oyeleye, A.; Normi, Y.M. Chitinase: Diversity, limitations, and trends in Engineering for suitable applications. Biosci. Rep. 2018, 38, 1–21. [Google Scholar] [CrossRef] [PubMed]
- Huang, Q.S.; Xie, X.L.; Liang, G.; Gong, F.; Wang, Y.; Wei, X.Q.; Wang, Q.; Ji, Z.L.; Chen, Q.X. The GH18 family of chitinases: Their domain architectures, functions and evolutions. Glycobiology 2012, 22, 23–34. [Google Scholar] [CrossRef]
- Kramer, K.J.; Muthukrishnan, S. Insect chitinases: Molecular biology and potential use as biopesticides. Insect Biochem. Mol. Biol. 1997, 27, 887–900. [Google Scholar] [CrossRef]
- Kabir, K.E.; Sugimoto, H.; Tado, H.; Endo, K.; Yamanaka, A.; Tanaka, S.; Koga, D. Effect of Bombyx mori Chitinase against Japanese Pine Sawyer (Monochamus alternatus) Adults as a Biopesticide. Biosci. Biotechnol. Biochem. 2006, 70, 219–229. [Google Scholar] [CrossRef]
- Liu, T.; Guo, X.; Bu, Y.; Zhou, Y.; Duan, Y.; Yang, Q. Structural and biochemical insights into an insect gut-specific chitinase with antifungal activity. Insect Biochem. Mol. Biol. 2020, 119, 103326. [Google Scholar] [CrossRef] [PubMed]
- Micocci, K.C.; Moreira, A.C.; Sanchez, A.D.; Pettinatti, J.L.; Rocha, M.C.; Dionizio, B.S.; Correa, K.C.S.; Malavazi, I.; Wouters, F.C.; Bueno, O.C.; et al. Identification, cloning, and characterization of a novel chitinase from leaf-cutting ant Atta sexdens: An enzyme with antifungal and insecticidal activity. Biochim. Biophys. Acta-Gen. Subj. 2023, 1867, 130249. [Google Scholar] [CrossRef] [PubMed]
- Castellani, A. Further researches on the long viability and growth of many pathogenic fungi and some bacteria in sterile distilled water. Mycopathol. Et Mycol. Appl. 1963, 20, 1–6. [Google Scholar] [CrossRef]
- Campana-filho, P.; Lavall, R.L.; Assis, O.B.G. b -Chitin from the pens of Loligo sp.: Extraction and characterization. Bioresour. Technol. 2007, 98, 2465–2472. [Google Scholar] [CrossRef]
- Facchinatto, W.M.; dos Santos, D.M.; Bukzem, A.d.L.; Moraes, T.B.; Habitzreuter, F.; de Azevedo, E.R.; Colnago, L.A.; Campana-Filho, S.P. Insight into morphological, physicochemical and spectroscopic properties of β-chitin nanocrystalline structures. Carbohydr. Polym. 2021, 273, 118563. [Google Scholar] [CrossRef]
- Souza, C.P.; Burbano-Rosero, E.M.; Almeida, B.C.; Martins, G.G.; Albertini, L.S.; Rivera, I.N.G. Culture medium for isolating chitinolytic bacteria from seawater and plankton. World J. Microbiol. Biotechnol. 2009, 25, 2079–2082. [Google Scholar] [CrossRef]
- McIlvaine, T.C. A Buffer Solution for Colorimetric Comparison. J. Biol. Chem. 1921, 49, 183–186. [Google Scholar] [CrossRef]
- Facchinatto, W.M.; dos Santos, D.M.; Fiamingo, A.; Bernardes-Filho, R.; Campana-Filho, S.P.; de Azevedo, E.R.; Colnago, L.A. Evaluation of chitosan crystallinity: A high-resolution solid-state NMR spectroscopy approach. Carbohydr. Polym. 2020, 250, 116891. [Google Scholar] [CrossRef]
- Osorio-Madrazo, A.; David, L.; Trombotto, S.; Lucas, J.M.; Peniche-Covas, C.; Domard, A. Kinetics study of the solid-state acid hydrolysis of chitosan: Evolution of the crystallinity and macromolecular structure. Biomacromolecules 2010, 11, 1376–1386. [Google Scholar] [CrossRef] [PubMed]
- Huggins, M.L. The Viscosity of Dilute Solutions of Long-Chain Molecules. IV. Dependence on Concentration. J. Am. Chem. Soc. 1942, 64, 2716–2718. [Google Scholar] [CrossRef]
- Rinaudo, M.; Milas, M.; Dung, P. Le Characterization of chitosan. Influence of ionic strength and degree of acetylation on chain expansion. Int. J. Biol. Macromol. 1993, 15, 281–285. [Google Scholar] [CrossRef] [PubMed]
- Miller, G.L. Use of Dinitrosalicylic Acid Reagent for Determination of Reducing Sugar. Anal. Chem. 1959, 31, 426–428. [Google Scholar] [CrossRef]
- Panwar, P.; Cui, H.; O’Donoghue, A.J.; Craik, C.S.; Sharma, V.; Brömme, D.; Guido, R.V.C. Structural requirements for the collagenase and elastase activity of cathepsin K and its selective inhibition by an exosite inhibitor. Biochem. J. 2014, 465, 163–173. [Google Scholar] [CrossRef]
- Bradford, M.M. A dye binding assay for protein. Anal. Biochem. 1976, 72, 248–254. [Google Scholar] [CrossRef]
- Mandels, M.; Weber, J. The Production of Cellulases. Gend. Educ. 1991, 7, 143–155. [Google Scholar]
- Karnovsky, M.J. The ultrastructural basis of capillary permeability studied with peroxidase as a tracer. J. Cell Biol. 1967, 35, 213–236. [Google Scholar] [CrossRef] [PubMed]
- Adrangi, S.; Faramarzi, M.A. From bacteria to human: A journey into the world of chitinases. Biotechnol. Adv. 2013, 31, 1786–1795. [Google Scholar] [CrossRef]
- Beckham, G.T.; Ståhlberg, J.; Knott, B.C.; Himmel, M.E.; Crowley, M.F.; Sandgren, M.; Sørlie, M.; Payne, C.M. Towards a molecular-level theory of carbohydrate processivity in glycoside hydrolases. Curr. Opin. Biotechnol. 2014, 27, 96–106. [Google Scholar] [CrossRef]
- Cardozo, F.A.; Facchinatto, W.M.; Colnago, L.A.; Campana-Filho, S.P.; Pessoa, A. Bioproduction of N-acetyl-glucosamine from colloidal α-chitin using an enzyme cocktail produced by Aeromonas caviae CHZ306. World J. Microbiol. Biotechnol. 2019, 35, 114. [Google Scholar] [CrossRef]
- Zeng, J.B.; He, Y.S.; Li, S.L.; Wang, Y.Z. Chitin whiskers: An overview. Biomacromolecules 2012, 13, 1–11. [Google Scholar] [CrossRef] [PubMed]
- Liu, F.C.; Su, C.R.; Wu, T.Y.; Su, S.G.; Yang, H.L.; Lin, J.H.Y.; Wu, T.S. Efficient 1H-NMR quantitation and investigation of N-Acetyl-D-glucosamine (GlcNAc) and N,N’-diacetylchitobiose (GlcNAc)2 from chitin. Int. J. Mol. Sci. 2011, 12, 5828–5843. [Google Scholar] [CrossRef] [PubMed]
- Abdelmalek, B.E.; Sila, A.; Haddar, A.; Bougatef, A.; Ayadi, M.A. β-Chitin and chitosan from squid gladius: Biological activities of chitosan and its application as clarifying agent for apple juice. Int. J. Biol. Macromol. 2017, 104, 953–962. [Google Scholar] [CrossRef] [PubMed]
- Focher, B.; Naggi, A.; Torri, G.; Cosani, A.; Terbojevich, M. Structural differences between chitin polymorphs and their precipitates from solutions-evidence from CP-MAS 13C-NMR, FT-IR and FT-Raman spectroscopy. Carbohydr. Polym. 1992, 17, 97–102. [Google Scholar] [CrossRef]
- Rinaudo, M. Chitin and chitosan: Properties and applications. Prog. Polym. Sci. 2006, 31, 603–632. [Google Scholar] [CrossRef]
- Focher, B.; Beltrame, P.L.; Naggi, A.; Torri, G. Alkaline N-deacetylation of chitin enhanced by flash treatments. Reaction kinetics and structure modifications. Carbohydr. Polym. 1990, 12, 405–418. [Google Scholar] [CrossRef]
- Saito, Y.; Putaux, J.L.; Okano, T.; Gaill, F.; Chanzy, H. Structural aspects of the swelling of β chitin in HCl and its conversion into α chitin. Macromolecules 1997, 30, 3867–3873. [Google Scholar] [CrossRef]
- Beier, S.; Bertilsson, S. Bacterial chitin degradation-mechanisms and ecophysiological strategies. Front. Microbiol. 2013, 4, 149. [Google Scholar] [CrossRef]
- Merzendorfer, H. Chitin metabolism in insects: Structure, function and regulation of chitin synthases and chitinases. J. Exp. Biol. 2003, 206, 4393–4412. [Google Scholar] [CrossRef]
- Phillips, A.J.L.; Alves, A.; Abdollahzadeh, J.; Slippers, B.; Wingfield, M.J.; Groenewald, J.Z.; Crous, P.W. The Botryosphaeriaceae: Genera and species known from culture. Stud. Mycol. 2013, 76, 51–167. [Google Scholar] [CrossRef]
- Gunamalai, L.; Duanis-Assaf, D.; Sharir, T.; Maurer, D.; Feygenberg, O.; Sela, N.; Alkan, N. Comparative characterization of virulent and less virulent. Mol. Plant Microbe Interact. 2023, 36, 502–515. [Google Scholar] [CrossRef]
- Meng, J.; Zhang, D.; Pan, J.; Wang, X.; Zeng, C.; Zhu, K.; Wang, F.; Liu, J.; Li, G. High-Quality Genome Sequence Resource of Lasiodiplodia theobromae JMB122, a Fungal Pathogen Causing Peach Gummosis. Mol. Plant-Microbe Interact. 2022, 35, 938–940. [Google Scholar] [CrossRef] [PubMed]
- Huda-Shakirah, A.R.; Mohamed Nor, N.M.I.; Zakaria, L.; Leong, Y.H.; Mohd, M.H. Lasiodiplodia theobromae as a causal pathogen of leaf blight, stem canker, and pod rot of Theobroma cacao in Malaysia. Sci. Rep. 2022, 12, 1–14. [Google Scholar] [CrossRef] [PubMed]
- Cardoso, J.E.; Bezerra, M.A.; Viana, F.M.P.; de Sousa, T.R.M.; Cysne, A.Q.; Farias, F.C. Ocorrência endofítica de Lasiodiplodia theobromae em tecidos de cajueiro e sua transmissão por propágulos. Summa Phytopathol. 2009, 35, 262–266. [Google Scholar] [CrossRef]
- Saha, S.; Sengupta, J.; Banerjee, D.; Khetan, A. Lasiodiplodia theobromae Keratitis: A Case Report and Review of Literature. Mycopathologia 2012, 174, 335–339. [Google Scholar] [CrossRef]
- Maurya, A.K.; Kumari, S.; Behera, G.; Bhadade, A.; Tadepalli, K. Rhino sinusitis caused by Lasiodiplodia theobromae in a diabetic patient. Med. Mycol. Case Rep. 2023, 40, 22–24. [Google Scholar] [CrossRef] [PubMed]
- Arakane, Y.; Muthukrishnan, S. Insect chitinase and chitinase-like proteins. Cell. Mol. Life Sci. 2010, 67, 201–216. [Google Scholar] [CrossRef] [PubMed]
- Singh, G.; Kumar, S. Biocatalysis and Agricultural Biotechnology Antifungal and insecticidal potential of chitinases: A credible choice for the eco-friendly farming. Biocatal. Agric. Biotechnol. 2019, 20, 101289. [Google Scholar] [CrossRef]
- Luong, N.N.; Tien, N.Q.D.; Huy, N.X.; Tue, N.H.; Man, L.Q.; Sinh, D.D.H.; Van Thanh, D.; Chi, D.T.K.; Hoa, P.T.B.; Loc, N.H. Expression of 42 kDa chitinase of Trichoderma asperellum (Ta-CHI42) from a synthetic gene in Escherichia coli. FEMS Microbiol. Lett. 2021, 368, fnab110. [Google Scholar] [CrossRef]
- Landim, P.G.C.; Correia, T.O.; Silva, F.D.A.; Nepomuceno, D.R.; Costa, H.P.S.; Pereira, H.M.; Lobo, M.D.P.; Moreno, F.B.M.B.; Brandão-Neto, J.; Medeiros, S.C.; et al. Production in Pichia pastoris, antifungal activity and crystal structure of a class I chitinase from cowpea (Vigna unguiculata): Insights into sugar binding mode and hydrolytic action. Biochimie 2017, 135, 89–103. [Google Scholar] [CrossRef]
- Gow, N.A.R.; Latge, J.; Munro, C.A.; Group, A.F.; Kingdom, U.; Group, A.F.; Kingdom, U. The Fungal Cell Wall: Structure, Biosynthesis, and Function. Microbiol. Spectr. 2017, 5. [Google Scholar] [CrossRef] [PubMed]
- Li, S.; Zhang, B.; Zhu, H.; Zhu, T. Cloning and expression of the Chitinase Encoded by ChiKJ406136 from Streptomyces Sampsonii (Millard & Burr) Waksman KJ40 and its antifungal effect. Forests 2018, 9, 699. [Google Scholar] [CrossRef]
- Takashima, T.; Henna, H.; Kozome, D.; Kitajima, S.; Uechi, K.; Taira, T. cDNA cloning, expression, and antifungal activity of chitinase from Ficus microcarpa latex: Difference in antifungal action of chitinase with and without chitin-binding domain. Planta 2021, 253, 120. [Google Scholar] [CrossRef] [PubMed]
- Sharma, A.; Arya, S.K.; Singh, J.; Kapoor, B.; Bhatti, J.S.; Suttee, A.; Singh, G. Prospects of chitinase in sustainable farming and modern biotechnology: An update on recent progress and challenges. Biotechnol. Genet. Eng. Rev. 2023, 1–31. [Google Scholar] [CrossRef] [PubMed]
- Le, B.; Yang, S.H. Microbial chitinases: Properties, current state and biotechnological applications. World J. Microbiol. Biotechnol. 2019, 35, 144. [Google Scholar] [CrossRef]

| Sample | CrISR (%) | CrIXRD (%) | L020 (nm) | L200 (nm) |
|---|---|---|---|---|
| βQ425 | 83.8 ± 1.7 | 71.2 | 4.70 | 3.43 |
| βQ425SE | 75.7 ± 9.0 | 66.4 | 4.30 | 3.80 |
| βQ425CE | 79.0 ± 9.4 | 37.8 | 7.13 | 5.32 |
| βQ125 | 80.7 ± 1.2 | 61.1 | 4.67 | 3.19 |
| βQ125SE | 76.3 ± 9.1 | 61.0 | 5.92 | 3.79 |
| βQ125CE | 79.5 ± 9.9 | 46.5 | 7.00 | 5.18 |
| QSigma | 85.7 ± 0.2 | 58.8 | 8.02 | 6.03 |
| QCenz | 75.1 ± 2.7 | 42.7 | 7.20 | 5.11 |
| Sample | η (mL.mg−1) | × 106 (g mol−1) | (%) | |
|---|---|---|---|---|
| BQ 125 | 3.30 ± 0.22 | 996 ± 92 | 6187 ± 581 | 94.3 ± 4.35 |
| BQ125SE | 1.28 ± 0.02 | 253 ± 5.0 | 1465 ± 198 | >95 |
| BQ425 | 5.06 ± 0.74 | 1860 ± 39 | 11,546 ± 2400 | 90.3 ± 3.74 |
| BQ425SE | 3.03 ± 0.07 | 876 ± 30 | 4319 ± 148 | >95 |
| AQ | 3.18 ± 0.18 | 943 ± 76.5 | 5858 ± 474 | 95.4 ± 5.28 |
| AQ SE | 0.57 ± 0.04 | 79.3 ± 7.8 | 492 ± 48 | >95 |
Disclaimer/Publisher’s Note: The statements, opinions and data contained in all publications are solely those of the individual author(s) and contributor(s) and not of MDPI and/or the editor(s). MDPI and/or the editor(s) disclaim responsibility for any injury to people or property resulting from any ideas, methods, instructions or products referred to in the content. |
© 2024 by the authors. Licensee MDPI, Basel, Switzerland. This article is an open access article distributed under the terms and conditions of the Creative Commons Attribution (CC BY) license (https://creativecommons.org/licenses/by/4.0/).
Share and Cite
Correa, K.C.S.; Facchinatto, W.M.; Habitzreuter, F.B.; Ribeiro, G.H.; Rodrigues, L.G.; Micocci, K.C.; Campana-Filho, S.P.; Colnago, L.A.; Souza, D.H.F. Activity of a Recombinant Chitinase of the Atta sexdens Ant on Different Forms of Chitin and Its Fungicidal Effect against Lasiodiplodia theobromae. Polymers 2024, 16, 529. https://doi.org/10.3390/polym16040529
Correa KCS, Facchinatto WM, Habitzreuter FB, Ribeiro GH, Rodrigues LG, Micocci KC, Campana-Filho SP, Colnago LA, Souza DHF. Activity of a Recombinant Chitinase of the Atta sexdens Ant on Different Forms of Chitin and Its Fungicidal Effect against Lasiodiplodia theobromae. Polymers. 2024; 16(4):529. https://doi.org/10.3390/polym16040529
Chicago/Turabian StyleCorrea, Katia Celina Santos, William Marcondes Facchinatto, Filipe Biagioni Habitzreuter, Gabriel Henrique Ribeiro, Lucas Gomes Rodrigues, Kelli Cristina Micocci, Sérgio Paulo Campana-Filho, Luiz Alberto Colnago, and Dulce Helena Ferreira Souza. 2024. "Activity of a Recombinant Chitinase of the Atta sexdens Ant on Different Forms of Chitin and Its Fungicidal Effect against Lasiodiplodia theobromae" Polymers 16, no. 4: 529. https://doi.org/10.3390/polym16040529
APA StyleCorrea, K. C. S., Facchinatto, W. M., Habitzreuter, F. B., Ribeiro, G. H., Rodrigues, L. G., Micocci, K. C., Campana-Filho, S. P., Colnago, L. A., & Souza, D. H. F. (2024). Activity of a Recombinant Chitinase of the Atta sexdens Ant on Different Forms of Chitin and Its Fungicidal Effect against Lasiodiplodia theobromae. Polymers, 16(4), 529. https://doi.org/10.3390/polym16040529

